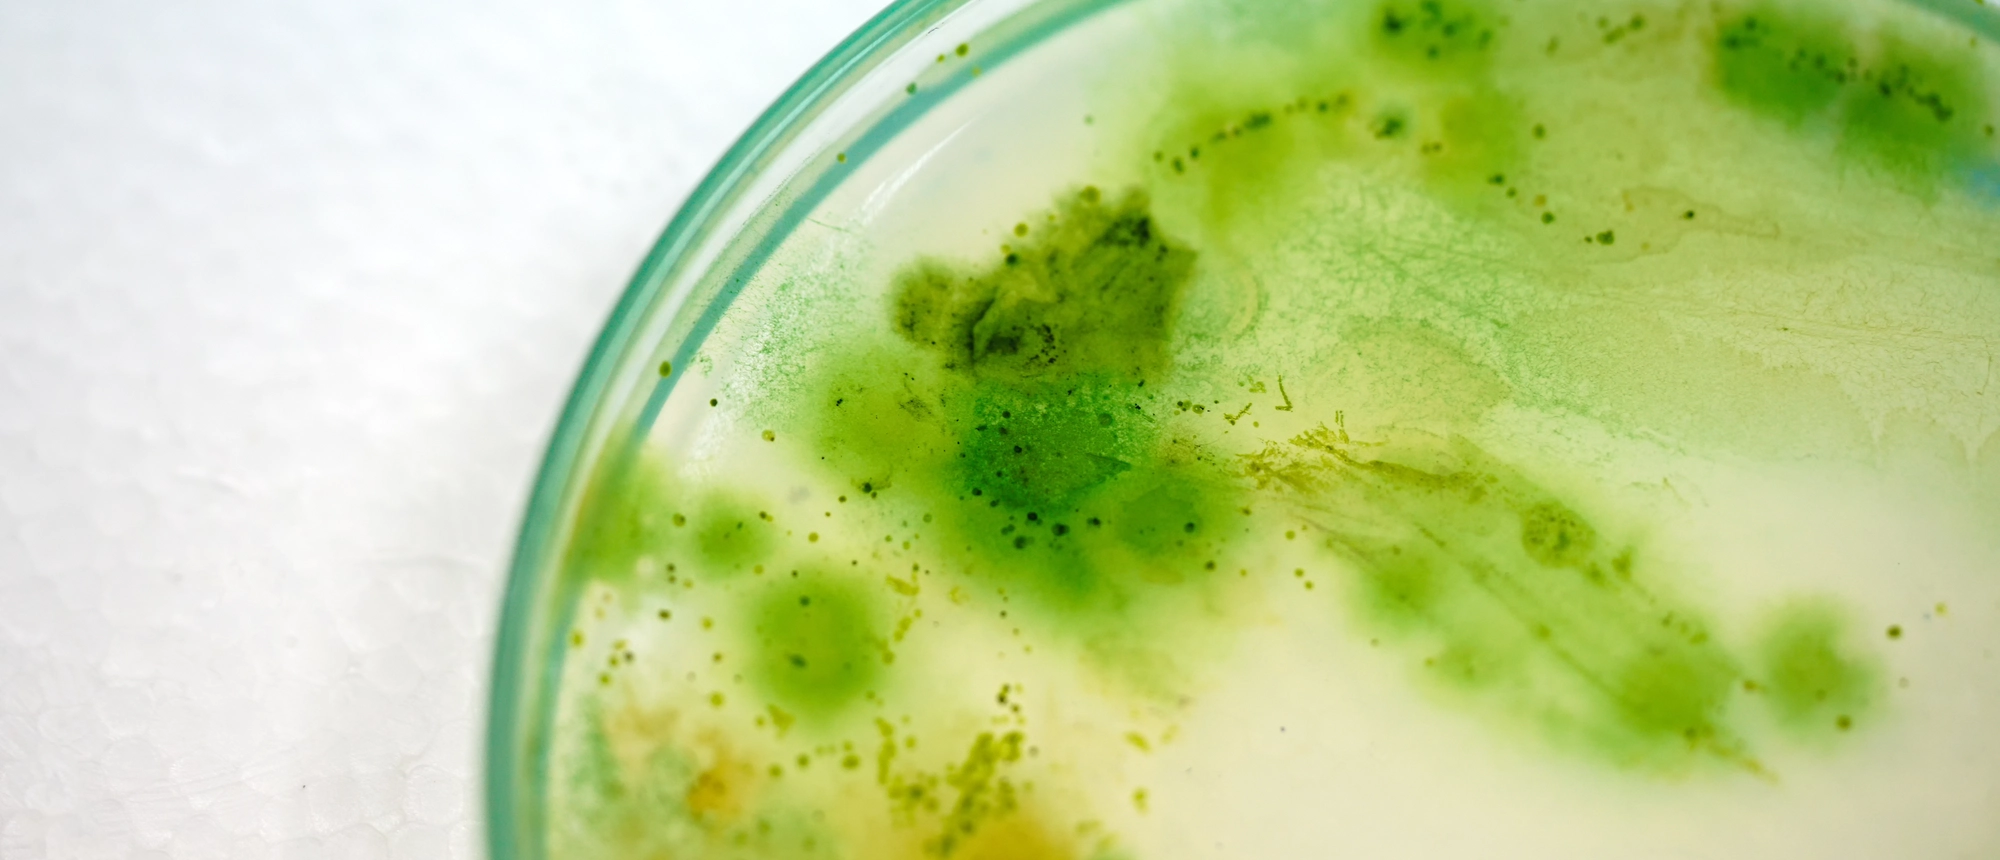
Legionella in drinking water - Mediagon

Legionella in drinking water
The Federal Office of Public Health is intensifying the fight against Legionella in Switzerland with the new project "LeCo".
According to the Federal Council, Legionella bacteria can also form in drinking water under certain circumstances. In such cases, fountains, steam rooms, and showers become potential sources of infection. Legionella can also multiply in cold water pipes if the water regularly heats up to higher temperatures.